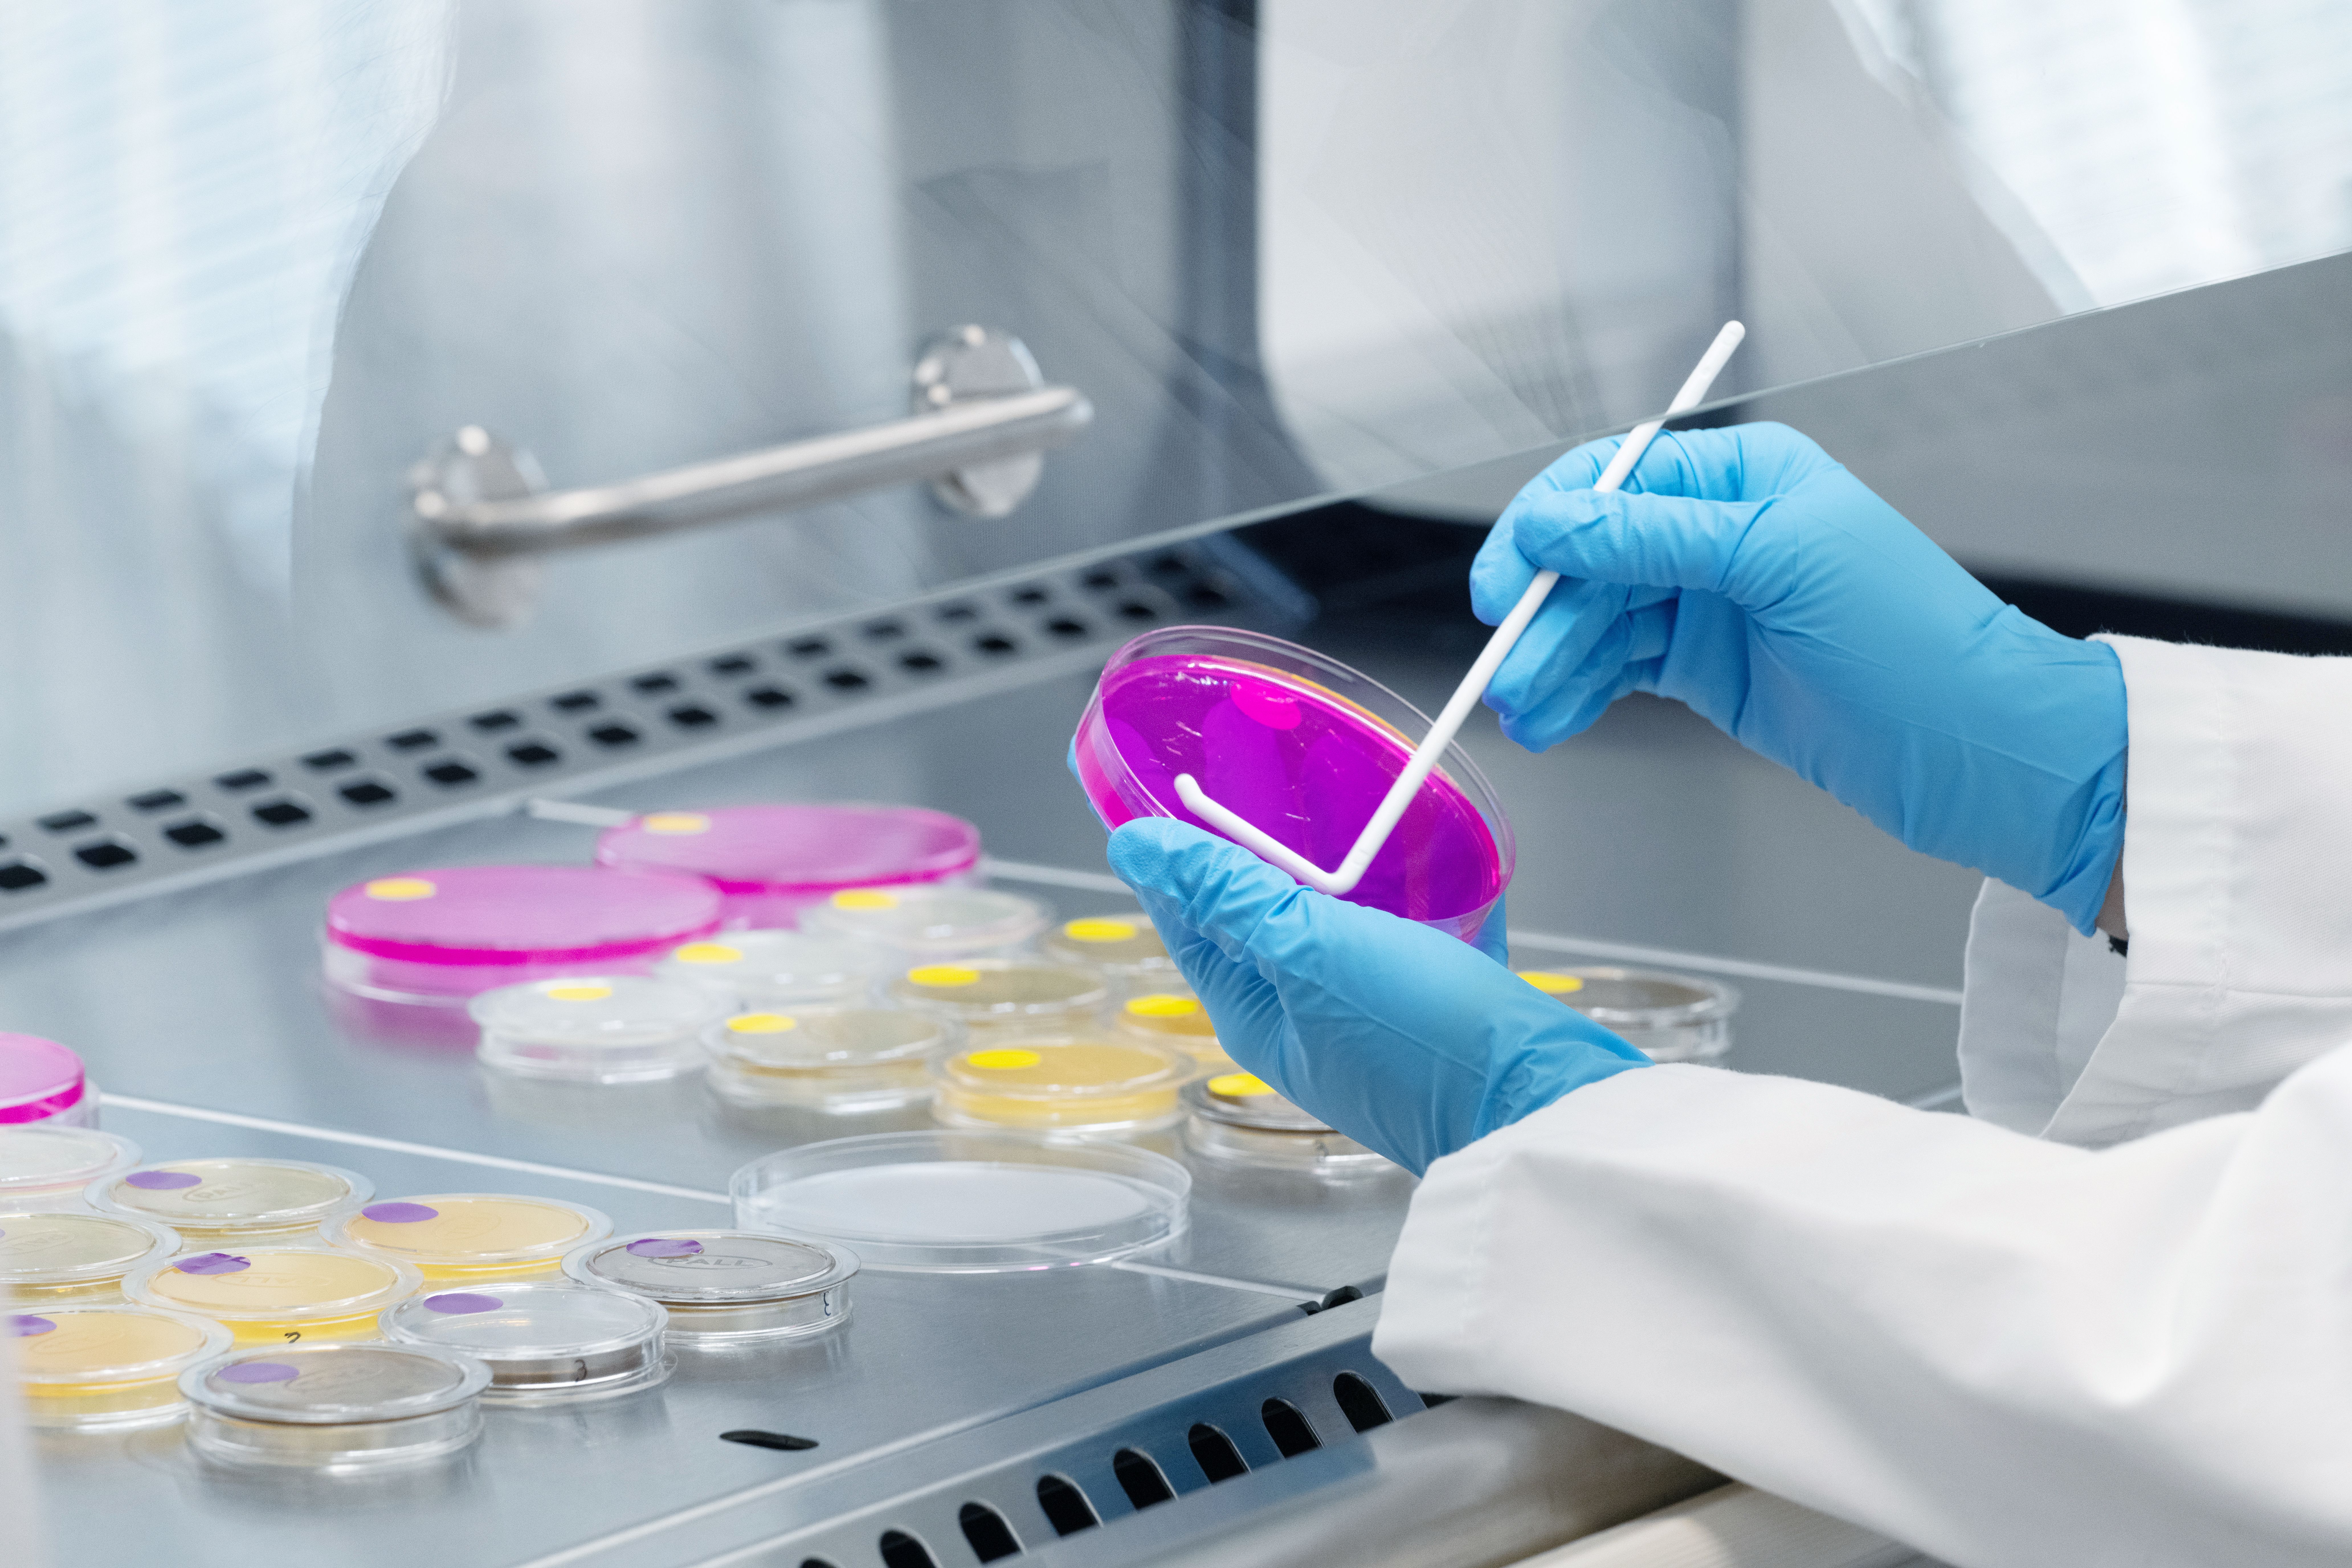

Historias Premium
Iberchem, 40 años de química creativa desde Murcia al mundo
La compañía celebra cuatro décadas convertida en un grupo global con 1.500 profesionales, producción en 23 países y una apuesta firme por la innovación, la sostenibilidad y la digitalización en el sector de las fragancias
En 1985, tres socios (Miguel Román, Ramón Fernández y José Robles) pusieron en marcha en Murcia una compañía de fragancias con vocación internacional desde el primer día. Cuatro décadas después, Iberchem celebra su 40 aniversario convertida en un grupo con más de 1.500 profesionales, presencia en 23 países y ventas en más de 120 mercados.
El crecimiento ha sido especialmente intenso en África, Oriente Medio, América Central y el sur de Asia, territorios que marcaron su expansión temprana y que hoy continúan como motores de desarrollo. Desde los años noventa, la firma ya operaba en el Magreb y el sudeste asiático, fruto de una estrategia que priorizó países emergentes frente a mercados más maduros y que hoy explica su ritmo sostenido de expansión.
La elección de Murcia como sede central tiene un sentido primordial. La ciudad está hermanada con Grasse, considerada capital mundial del perfume por su tradición en materias primas aromáticas. La región murciana aporta plantas aromáticas y cítricos esenciales para la formulación, un entorno que ha favorecido el arraigo de la compañía y su conexión con la cadena de suministro desde el origen. Esta proximidad a las materias primas ha permitido consolidar un conocimiento técnico ligado al territorio y proyectarlo a escala internacional.

Hoy, en esa sede conviven más de 30 nacionalidades y una media de edad en torno a los 34 o 35 años. “Es una empresa muy ágil por su tamaño”, afirma Guillaume Audy, director de Corporate Communications and Sustainability. “Nos permite adaptarnos a los modelos de los países donde trabajamos”. Esa flexibilidad resulta clave en mercados emergentes con dinámicas empresariales diversas y realidades culturales propias, donde la comprensión del contexto local forma parte del desarrollo del producto.
La compañía estructura su actividad en cuatro grandes categorías: perfumería fina, cuidado del hogar, cuidado corporal y ambientación. El corazón de la organización lo forman sus perfumistas, conocidos en el sector como “narices”. Son químicos especializados en descomponer y construir acordes olfativos con una precisión que roza la artesanía científica. “Son gente que tiene una capacidad muy sorprendente, muy alta, de detectar los componentes químicos de un olor”, explica Audy. Esa combinación de formulación y sensibilidad define el lema corporativo: creatividad a través de la ciencia.
El trabajo va más allá de la fragancia en sí. Iberchem desarrolla tecnologías complementarias que aportan funcionalidades específicas: efecto blooming, mayor duración o sistemas de encapsulación para detergentes que liberan el aroma con la fricción. En este ámbito se sitúan avances como Vernova®Pure Pro, evolución de su tecnología biodegradable de neutralización de malos olores.
Sostenibilidad y digitalización
La apuesta por la sostenibilidad recorre toda la cadena de valor. El programa Elixia impulsa el trabajo directo con proveedores de materias primas, como el cardamomo en Guatemala, para profundizar en el conocimiento de origen y reforzar buenas prácticas. En paralelo, el laboratorio IB-BI permite evaluar internamente la biodegradabilidad de las fragancias según los estándares de la OCDE y ampliar la cartera de soluciones alineadas con criterios ambientales exigentes. “Poder probar la biodegradabilidad de las fragancias internamente nos permite ampliar la cartera de fragancias sostenibles y biodegradables Green Future de Iberchem. IB-BI es un gran ejemplo de nuestros esfuerzos por reducir la huella de carbono no solo de nuestras actividades comerciales, sino también de nuestros productos”, destacan desde la compañía.
La digitalización ocupa un lugar central en la estrategia, ya que todas las operaciones globales se articulan sobre SAP y se apoyan en equipos de coordinación transversal que garantizan una gestión integrada en cada mercado. A ello se suma NEXALIS, una plataforma que centraliza la documentación técnica y económica de cada pedido para los clientes, con acceso directo a fichas técnicas, certificados o facturas y seguimiento del estado de solicitudes. La automatización también facilita el trabajo creativo y permite a los perfumistas consultar materias primas compatibles para optimizar el desarrollo de fórmulas.
En el ámbito científico, Iberchem ha lanzado Wavemotion®, programa de investigación en neurociencia que analiza cómo las fragancias activan el sistema límbico y condicionan la respuesta emocional. El objetivo es respaldar con datos fisiológicos y neuronales los argumentos de bienestar asociados a las fragancias.

La compañía trabaja con marcas de distribución y parafarmacia de amplia presencia en el mercado, aunque por motivos de confidencialidad no es posible citar a la mayoría de sus clientes. Como proyecto destacado, ha participado recientemente en el desarrollo de fragancias para un parque temático de Harry Potter en Alemania, uno de los pocos casos que puede hacerse público.
En paralelo, Iberchem prepara la ampliación de su planta en China, un nuevo centro creativo en Barcelona y la expansión de sus instalaciones en Murcia. “Tenemos un crecimiento fuerte a doble dígito a nivel de ventas y queremos mantener ese ritmo a largo plazo”, concluye Audy. La fórmula combina innovación tecnológica, desarrollo de talento joven y arraigo territorial con proyección global.
Cuarenta años después de su fundación, la química creativa de Iberchem continúa explorando cómo un aroma puede conectar ciencia, cultura y emoción en cualquier punto del planeta.


